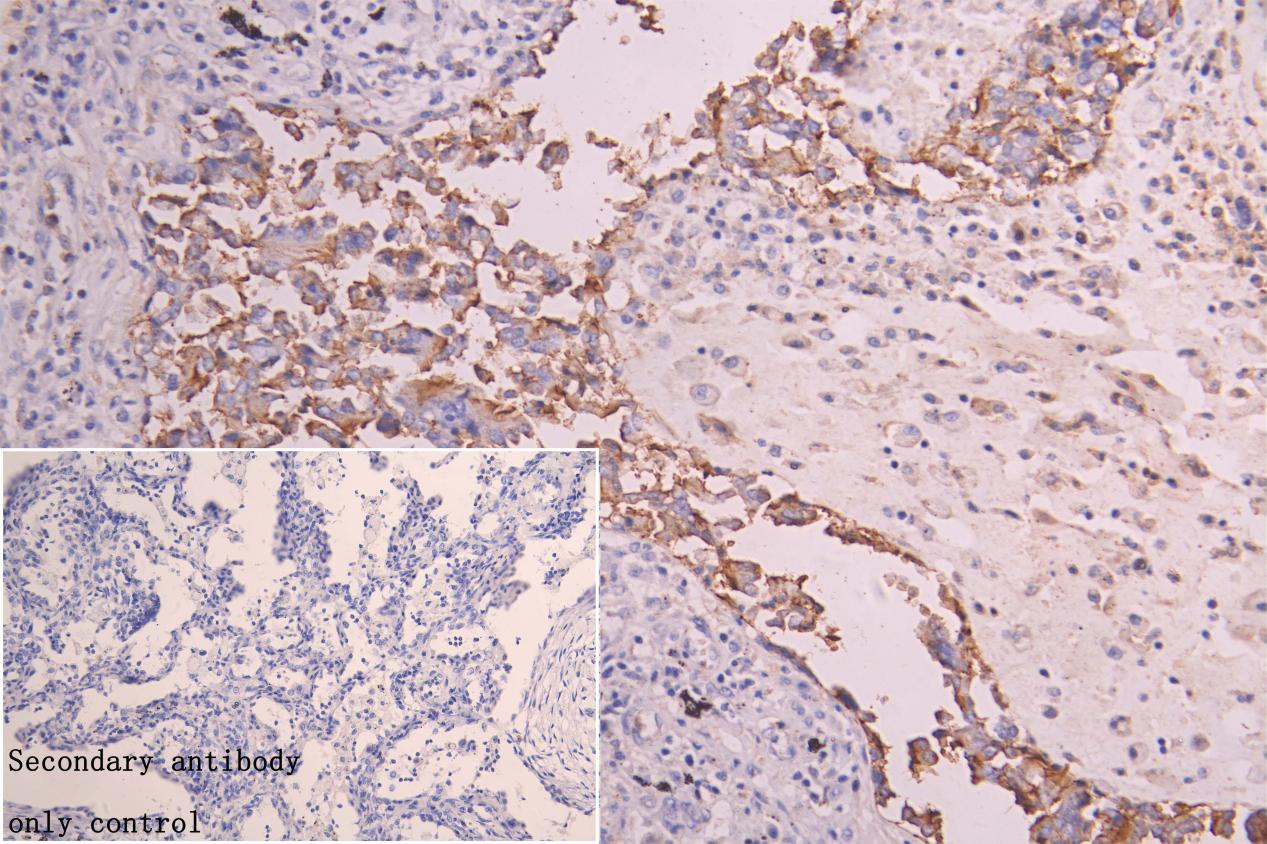

-
中文名稱:ALDH3B1兔多克隆抗體
-
貨號:CSB-PA001574LA01HU
-
規格:¥3900
-
圖片:
-
Western Blot
Positive WB detected in: RAW264.7 whole cell lysate, MCF7 whole cell lysate, A549 whole cell lysate, Hela whole cell lysate, HepG2 whole cell lysate
All lanes:ALDH3B1 Antibody at 1:1000
Secondary
Goat polyclonal to rabbit IgG at 1/50000 dilution
Predicted band size: 52 kDa
Observed band size: 52 kDa -
IHC image of CSB-PA001574LA01HU diluted at 1:50 and staining in paraffin-embedded human Lung cancer performed on a Leica BondTM system. After dewaxing and hydration, antigen retrieval was mediated by high pressure in a citrate buffer (pH 6.0). Section was blocked with 10% normal goat serum 30min at RT. Then primary antibody (1% BSA) was incubated at 4°C overnight. The primary is detected by a Goat anti-rabbit polymer IgG labeled by HRP and visualized using 0.05% DAB. Secondary antibody only control: uses 1% BSA instead of primary antibody
-
IHC image of CSB-PA001574LA01HU diluted at 1:150 and staining in paraffin-embedded mouse liver tissue performed on a Leica BondTM system. After dewaxing and hydration, antigen retrieval was mediated by high pressure in a citrate buffer (pH 6.0). Section was blocked with 10% normal goat serum 30min at RT. Then primary antibody (1% BSA) was incubated at 4°C overnight. The primary is detected by a Goat anti-rabbit polymer IgG labeled by HRP and visualized using 0.05% DAB. Secondary antibody only control: uses 1% BSA instead of primary antibody
-
-
其他:
產品詳情
-
產品描述:
CUSABIO is glad to provide a highly specific antibody directed against an epitope of human ALDH3B1 protein. The polyclonal antibody (CSB-PA001574LA01HU) is raised in the rabbit against a peptide mapping within amino acid residues 168-449 of human ALDH3B1. It exists as an unconjugated IgG isotype. Its purity is 95%+ using protein G purified. This ALDH3B1 antibody has undergone rigorous quality validations in ELISA, IF, and WB analyses. And it has been designed to recognize ALDH3B1 from human, mouse, and rat samples. Its target protein plays an important role in the defense against oxidative stress, specifically lipid peroxidation-derived aldehydes.
-
產品名稱:Rabbit anti-Homo sapiens (Human) ALDH3B1 Polyclonal antibody
-
Uniprot No.:
-
基因名:ALDH3B1
-
別名:ALDH3B1 antibody; ALDH7Aldehyde dehydrogenase family 3 member B1 antibody; EC 1.2.1.28 antibody; EC 1.2.1.5 antibody; EC 1.2.1.7 antibody; Aldehyde dehydrogenase 7 antibody
-
宿主:Rabbit
-
反應種屬:Human, Mouse
-
免疫原:Recombinant Human Aldehyde dehydrogenase family 3 member B1 protein
-
免疫原種屬:Homo sapiens (Human)
-
克隆類型:Polyclonal
-
抗體亞型:IgG
-
純化方式:Antigen?affinity?purification
-
濃度:It differs from different batches. Please contact us to confirm it.
-
保存緩沖液:Preservative:0.02%?sodium?azide
Constituents:?PBS?containing?50%?glycerol pH 7.3 -
產品提供形式:Liquid
-
應用范圍:ELISA, WB, IHC
-
推薦稀釋比:
Application Recommended Dilution WB 1:1000-1:2000 IHC 1:20-1:200 -
Protocols:
-
儲存條件:Upon receipt, store at -20°C or -80°C. Avoid repeated freeze.
-
貨期:Basically, we can dispatch the products out in 1-3 working days after receiving your orders. Delivery time maybe differs from different purchasing way or location, please kindly consult your local distributors for specific delivery time.
-
用途:For Research Use Only. Not for use in diagnostic or therapeutic procedures.
相關產品
靶點詳情
-
功能:Oxidizes medium and long chain saturated and unsaturated aldehydes. Metabolizes also benzaldehyde. Low activity towards acetaldehyde and 3,4-dihydroxyphenylacetaldehyde. May not metabolize short chain aldehydes. Can use both NADP(+) and NAD(+) as electron acceptor. May have a protective role against the cytotoxicity induced by lipid peroxidation.
-
基因功能參考文獻:
- the likely physiological function of ALDH3B1 is to oxidize lipid-derived aldehydes generated in the plasma membrane and not to be involved in the sphingolipid metabolism in the endoplasmic reticulum. PMID: 23721920
- protects cells from the damaging effects of oxidative stress PMID: 20699116
- The specificity of ALDH3B1 distribution may prove to be directly related to the functional role of this enzyme in human tissues. PMID: 20729348
- This study shows for the first time the functionality, expression and protective role of ALDH3B1 and indicates a potential physiological role of ALDH3B1 against oxidative stress. PMID: 17382292
- These findings provided convincing evidence that epistasis between the catechol-O-methyltransferase and aldehyde dehydrogenase 3B1 genes plays an important role in the pathogenesis of schizophrenia PMID: 19159868
- Initial characterization of human ALDH3B1 suggests a potential physiological role of this protein in oxidative stress processes. PMID: 17382292
顯示更多
收起更多
-
亞細胞定位:Cell membrane; Lipid-anchor. Note=Primarily in the plasma membrane as well as in some punctate structures in the cytoplasm.
-
蛋白家族:Aldehyde dehydrogenase family
-
組織特異性:Highest expression in kidney and lung.
-
數據庫鏈接:
Most popular with customers
-
-
YWHAB Recombinant Monoclonal Antibody
Applications: ELISA, WB, IHC, IF, FC
Species Reactivity: Human, Mouse, Rat
-
Phospho-YAP1 (S127) Recombinant Monoclonal Antibody
Applications: ELISA, WB, IHC
Species Reactivity: Human
-
-
-
-
-